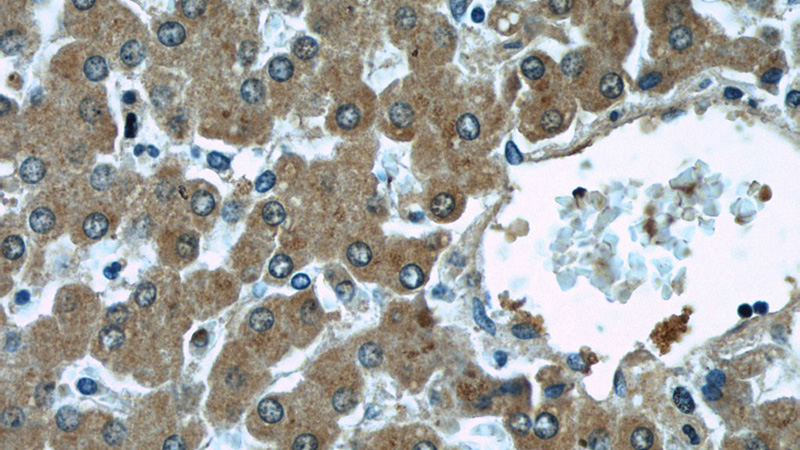
Immunohistochemical of paraffin-embedded human liver using Catalog No:112456(MAGT1 antibody) at dilution of 1:50 (under 40x lens)

-
Product Name
MAGT1 antibody
- Documents
-
Description
MAGT1 Rabbit Polyclonal antibody. Positive IF detected in HepG2 cells. Positive IHC detected in human liver tissue, human skeletal muscle tissue. Positive WB detected in Jurkat cells, HEK-293 cells, HeLa cells, HT-1080 cells, human liver tissue, mouse brain tissue, mouse colon tissue, mouse heart tissue, mouse kidney tissue. Observed molecular weight by Western-blot: 45-47 kDa
-
Tested applications
ELISA, WB, IHC, IF
-
Species reactivity
Human,Mouse,Rat; other species not tested.
-
Alternative names
bA217H1.1 antibody; DKFZp564K142 antibody; FLJ14726 antibody; IAG2 antibody; IAP antibody; magnesium transporter 1 antibody; MAGT1 antibody; OST3B antibody; PRO0756 antibody; UNQ628/PRO1244 antibody
-
Isotype
Rabbit IgG
-
Preparation
This antibody was obtained by immunization of MAGT1 recombinant protein (Accession Number: NM_001367916). Purification method: Antigen affinity purified.
-
Clonality
Polyclonal
-
Formulation
PBS with 0.02% sodium azide and 50% glycerol pH 7.3.
-
Storage instructions
Store at -20℃. DO NOT ALIQUOT
-
Applications
Recommended Dilution:
WB: 1:500-1:5000
IHC: 1:20-1:200
IF: 1:10-1:100
-
Validations

Jurkat cells were subjected to SDS PAGE followed by western blot with Catalog No:112456(MAGT1 antibody) at dilution of 1:1000

Immunohistochemical of paraffin-embedded human liver using Catalog No:112456(MAGT1 antibody) at dilution of 1:50 (under 10x lens)
Immunohistochemical of paraffin-embedded human liver using Catalog No:112456(MAGT1 antibody) at dilution of 1:50 (under 40x lens)

Immunofluorescent analysis of HepG2 cells, using Catalog No:112456 and Rhodamine-labeled goat anti-rabbit IgG (red).Blue pseudocolor = DAPI (fluorescent DNA dye).
-
Background
MAGT1 is a mammalian Mg2+-selective transporter being required for cellular magnesium uptake and vertebrate embryonic development. It possesses five putative transmembrane (TM) regions with a cleavage site, a N-glycosylation site, and a number of phosphorylation sites. Western blot analysis revealed a 38-kD Magt1 protein in all mouse tissues as well as a 35-kD protein in some tissues.Recently mutations in MAGT1 has been found to be asscociated with a novel X-linked human immunodeficiency. The MAGT1 protein was undetectable in the patients’ cells by western blot or immunofluorescent cell surface staining(Nature 475, 471-6 ).
-
References
- Cherepanova NA, Shrimal S, Gilmore R. Oxidoreductase activity is necessary for N-glycosylation of cysteine-proximal acceptor sites in glycoproteins. The Journal of cell biology. 206(4):525-39. 2014.
- Cherepanova NA, Gilmore R. Mammalian cells lacking either the cotranslational or posttranslocational oligosaccharyltransferase complex display substrate-dependent defects in asparagine linked glycosylation. Scientific reports. 6:20946. 2016.
- Li FY, Chaigne-Delalande B, Kanellopoulou C. Second messenger role for Mg2+ revealed by human T-cell immunodeficiency. Nature. 475(7357):471-6. 2011.
Related Products / Services
Please note: All products are "FOR RESEARCH USE ONLY AND ARE NOT INTENDED FOR DIAGNOSTIC OR THERAPEUTIC USE"
